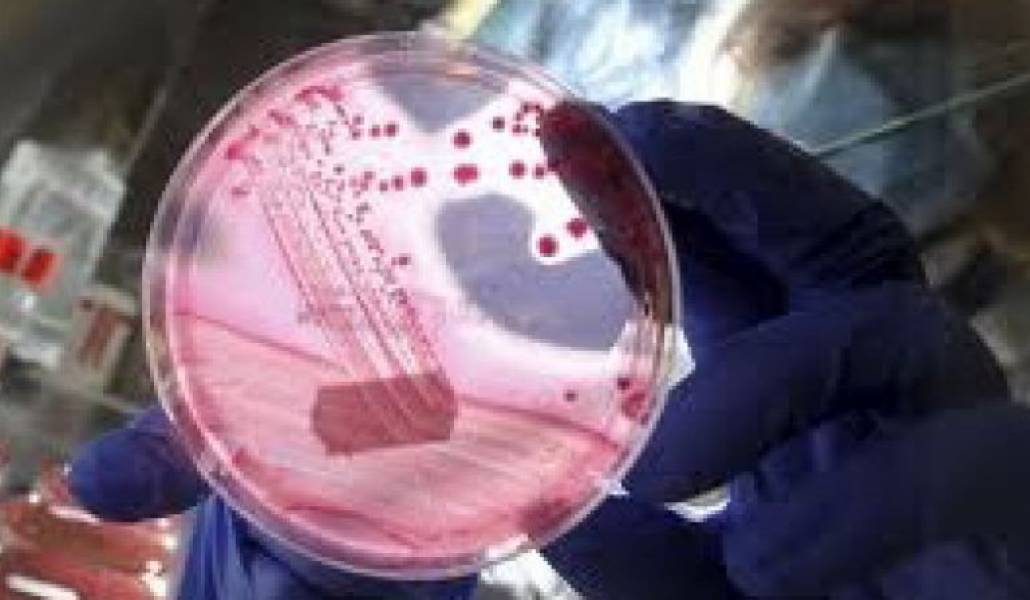
64b5d39975deb29cf176a10c4e646c3c

Beansprouts likely cause of deadly E. Coli outbreak
Beansprouts grown in northern Germany are said to be the source of an E. coli outbreak throughout Europe.
Gert Hahne, a spokesman for the Lower Saxony agriculture ministry, told the Associated Press news agency that the reason for the outbreak were likely beansprouts imported from Saxony and used in salads. Hahne promised to present the final conclusion a bit later.
The beansprouts include adzuki, alfalfa, broccoli, peas, lentils and mung beans which are laregely used in salads.
More than 2,150 people in Germany have been infected by Enterohemorrhagic Escherichia Coli infection that has left 21 victims in Germany and one in Sweden. Many have developed haemolytic-uraemic syndrome (HUS), which can be fatal.
Cases have been concentrated in Hamburg, with infections in 12 other countries linked to travel in Germany.
Scientists say the new E. coli strain is an aggressive hybrid form toxic to humans and not previously linked to food poisoning.
Earlier, specialists said that the deadly E.coli was caused by contaminated cucumbers, potatoes and other vegetables and immediately put a ban on their import.



